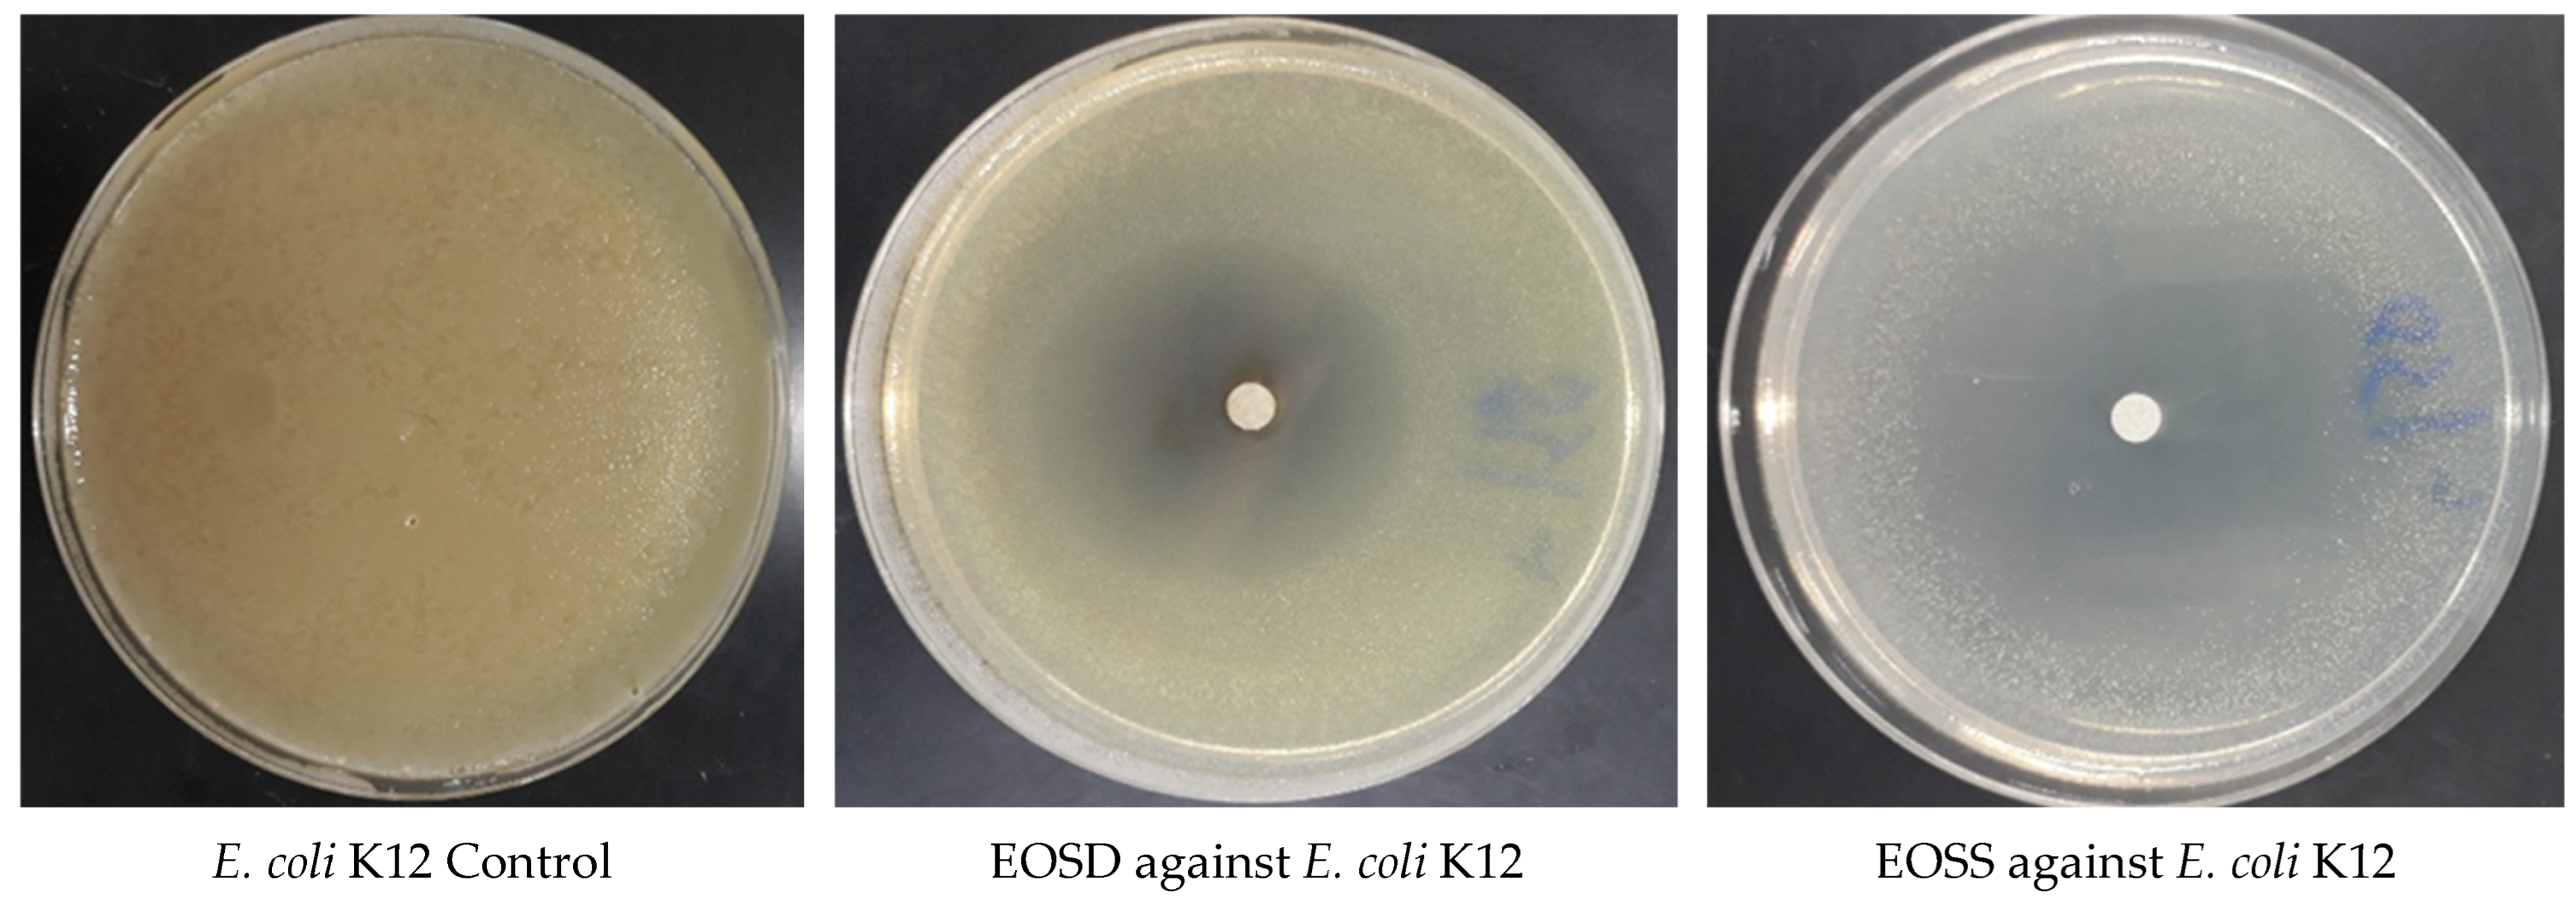

Phytochemistry and Biological Activities of Essential Oils from Satureja calamintha Nepeta
Abstract
1. Introduction
2. Materials and Methods
2.1. Plant Material
2.2. Seed Germination
2.3. Extraction of Essential Oils
2.4. GC–MS Analysis of Essential Oils
2.5. Antioxydant Activity
2.5.1. DPPH Test
2.5.2. FRAP Test
2.6. Antimicrobial Activity of Essential Oils of S. calamintha
2.6.1. Disk Diffusion Test
2.6.2. Determination of the Minimum Inhibitory Concentration (MIC)
2.7. In Silico Molecular Docking of Antioxidant and Antimicrobial Activities of EO of Wild and Domesticated S. calamintha
2.8. Statistical Analysis
3. Results and Discussion
3.1. Phytochemical Characterization of EOs
3.2. Antioxidant Activity
3.3. Antibacterial Activity
3.4. Antifungal Activity
3.5. In Silico Molecular Docking of Antioxidant and Antimicrobial Activities of EOs of Wild and Domesticated S. calamintha
4. Conclusions
Author Contributions
Funding
Institutional Review Board Statement
Informed Consent Statement
Data Availability Statement
Acknowledgments
Conflicts of Interest
References
- Gormez, A.; Bozari, S.; Yanmis, D.; Gulluce, M.; Sahin, F.; Agar, G. Chemical Composition and Antibacterial Activity of Essential Oils of Two Species of Lamiaceae against Phytopathogenic Bacteria. Pol. J. Microbiol. 2015, 64, 121–127. [Google Scholar] [CrossRef]
- Kaya, A.; Satil, F.; Gogel, F. Nutlet Surface Micromorphology of Turkish Satureja (Lamiaceae). Biologia 2009, 64, 902–907. [Google Scholar] [CrossRef]
- Bellakhdar, J. Contribution to the Study of the Traditional Pharmacopoeia in Morocco: Current Situation, Products, Sources of Knowledge. Ethnobotanical Field Survey Conducted from 1969 to 1992. Ph.D. Thesis, University of Metz, Metz, France, 1997; 1157p. [Google Scholar]
- Bojović, D.; Šoškić, M.; Tadić, V. Comparative Study of Chemical Composition of the Essential Oils from Satureja Cuneifolia Ten. and Satureja montana L., Lamiaceae Collected at National Park Lovcen, Montenegro. Stud. Univ. Babes-Bolyai Chem. 2018, 63, 167–180. [Google Scholar] [CrossRef]
- Babajafari, S.; Nikaein, F.; Mazloomi, S.M.; Zibaeenejad, M.J.; Zargaran, A. A Review of the Benefits of Satureja Species on Metabolic Syndrome and Their Possible Mechanisms of Action. J. Evidence-Based Complement. Altern. Med. 2015, 20, 212–223. [Google Scholar] [CrossRef]
- Bougandoura, N.; Bendimerad, N. Evaluation of the Antioxidant Activity of Aqueous and Methanolic Extracts of Satureja calamintha ssp. Nepeta (L.) Briq. Nat. Technol. 2013, 9, 14–19. [Google Scholar]
- Bouzidi, N.; Kemieg, M. Antioxidant and Antimicrobial Activities of Essential Oil of Satureja calamintha ssp. Nepeta (L.) Briq. from the Northwest of Algeria. Agric. Conspec. Sci. 2021, 86, 349–356. [Google Scholar]
- Abbad, A.; Belaqziz, R.; Bekkouche, K.; Markouk, M. Influence of Temperature and Water Potential on Laboratory Germination of Two Moroccan Endemic Thymes: Thymus Maroccanus Ball. And Thymus Broussonetii Boiss. Afr. J. Agric. Res. 2011, 6, 4740–4745. [Google Scholar] [CrossRef]
- Kerbouche, L.; Hazzit, M.; Baaliouamer, A. Essential Oil of Satureja calamintha subsp. Nepeta (L.) Briq. from Algeria: Analysis, Antimicrobial and Antioxidant Activities. J. Biol. Act. Prod. Nat. 2013, 3, 266–272. [Google Scholar] [CrossRef]
- Bouzidi, N.; Mederbal, K.; Bouhadi, D. Chemical Composition of the Essential Oil of Satureja Calamintha Subsp. Nepeta of West Algerian. Moroc. J. Chem. 2018, 6, 213–217. [Google Scholar]
- Bakkali, F.; Averbeck, S.; Averbeck, D.; Idaomar, M. Biological Effects of Essential Oils—A Review. Food Chem. Toxicol. 2008, 46, 446–475. [Google Scholar] [CrossRef]
- Bouyahya, A.; Bakri, Y.; Belmehdi, O.; Et-Touys, A.; Abrini, J.; Dakka, N. Phenolic Extracts of Centaurium Erythraea with Novel Antiradical, Antibacterial and Antileishmanial Activities. Asian Pac. J. Trop. Dis. 2017, 7, 433–439. [Google Scholar] [CrossRef]
- Bouyahya, A.; Abrini, J.; Bakri, Y.; Dakka, N. Essential Oils as Anticancer Agents: News on Mode of Action. Phytotherapie 2016, 16, 254–267. [Google Scholar] [CrossRef]
- Boudjema, K.; Bouanane, A.; Gamgani, S.; Djeziri, M.; Mustapha, M.A.; Fazouane, F. Phytochemical Profile and Antimicrobial Properties of Volatile Compounds of Satureja calamintha (L) Scheel from Northern Algeria. Trop. J. Pharm. Res. 2018, 17, 857–864. [Google Scholar] [CrossRef]
- Amorati, R.; Foti, M.C.; Valgimigli, L. Antioxidant Activity of Essential Oils. J. Agric. Food Chem. 2013, 61, 10835–10847. [Google Scholar] [CrossRef] [PubMed]
- Hamilton, A.C. Medicinal Plants, Conservation and Livelihoods. Biodivers. Conserv. 2004, 13, 1477–1517. [Google Scholar] [CrossRef]
- Fennell, C.W.; Lindsey, K.L.; McGaw, L.J.; Sparg, S.G.; Stafford, G.I.; Elgorashi, E.E.; Grace, O.M.; Van Staden, J. Assessing African Medicinal Plants for Efficacy and Safety: Pharmacological Screening and Toxicology. J. Ethnopharmacol. 2004, 94, 205–217. [Google Scholar] [CrossRef] [PubMed]
- Chebbac, K.; Ghneim, H.K.; El Moussaoui, A.; Bourhia, M.; El Barnossi, A.; Ouaritini, Z.B.; Salamatullah, A.M.; Alzahrani, A.; Aboul-Soud, M.A.M.; Giesy, J.P.; et al. Antioxidant and Antimicrobial Activities of Chemically-Characterized Essential Oil from Artemisia Aragonensis Lam. against Drug-Resistant Microbes. Molecules 2022, 27, 1136. [Google Scholar] [CrossRef]
- Wang, H.; Gao, X.D.; Zhou, G.C.; Cai, L.; Yao, W.B. In Vitro and In Vivo Antioxidant Activity of Aqueous Extract from Choerospondias Axillaris Fruit. Food Chem. 2008, 106, 888–895. [Google Scholar] [CrossRef]
- Moattar, F.S.; Sariri, R.; Yaghmaee, P.; Giahi, M. Enzymatic and Non-Enzymatic Antioxidants of Calamintha officinalis Moench Extracts. J. Appl. Biotechnol. Rep. 2016, 3, 489–494. [Google Scholar]
- Lafraxo, S.; El Barnossi, A.; El Moussaoui, A.; Bourhia, M.; Salamatullah, A.M.; Alzahrani, A.; Akka, A.A.; Choubbane, A.; Akhazzane, M.; Aboul-soud, M.A.M.; et al. Essential Oils from Leaves of Juniperus thurifera L., Exhibiting Antioxidant, Antifungal and Antibacterial Activities against Antibiotic-Resistant Microbes. Horticulturae 2022, 8, 321. [Google Scholar] [CrossRef]
- Moussaid, F.; El Atki, Y.; El Barnossi, A.; Abdellaoui, A.; Iraqi Housseini, A. In Vitro Antifungal Activity of Cinnamum burmannii and Cuminum Cyminum Essential Oils against Two Nosocomial Strains of Aspergillus fumigatus. Artic. J. Pharm. Sci. Res. 2019, 11, 9–12. [Google Scholar]
- Rossi, P.G.; Berti, L.; Panighi, J.; Luciani, A.; Maury, J.; Muselli, A.; Serra, D.D.R.; Gonny, M.; Bolla, J.M. Antibacterial Action of Essential Oils from Corsica. J. Essent. Oil Res. 2007, 19, 176–182. [Google Scholar] [CrossRef]
- Couladis, M.; Tzakou, O. Essential Oil of Calamintha nepeta subsp. Glandulosa from Greece. J. Essent. Oil Res. 2001, 13, 11–12. [Google Scholar] [CrossRef]
- El Barnossi, A.; Moussaid, F.; Iraqi Housseini, A. Tangerine, Banana and Pomegranate Peels Valorisation for Sustainable Environment: A Review. Biotechnol. Rep. 2021, 29, e00574. [Google Scholar] [CrossRef] [PubMed]
- Abd El-Aziz, N.M.; Eldin Awad, O.M.; Shehata, M.G.; El-Sohaimy, S.A. Antioxidant and Anti-Acetylcholinesterase Potential of Artichoke Phenolic Compounds. Food Biosci. 2021, 41, 101006. [Google Scholar] [CrossRef]
- Abdel-Rahman, L.H.; Basha, M.T.; Al-Farhan, B.S.; Shehata, M.R.; Mohamed, S.K.; Ramli, Y. [Cu (Dipicolinoylamide)(NO3)(H2O)] as Anti-COVID-19 and Antibacterial Drug Candidate: Design, Synthesis, Crystal Structure, DFT and Molecular Docking. J. Mol. Struct. 2022, 1247, 131348. [Google Scholar] [CrossRef] [PubMed]
- Mahmoud, W.H. Metal Complexes of Novel Schiff Base Derived from Iron Phenylenediamine: Synthesis, Characterization, DFT Studies, Antimicrobial Activities and Molecular Docking. Appl. Organomet. Chem. 2018, 32, e4289. [Google Scholar] [CrossRef]
- Aboul-soud, M.A.M.; Ennaji, H.; Kumar, A.; Alfhili, M.A.; Bari, A.; Ahamed, M.; Chebaibi, M.; Bourhia, M.; Khallouki, F.; Alghamdi, K.M.; et al. Antioxidant, Anti-Proliferative Activity and Chemical Fingerprinting of Centaurea Calcitrapa against Breast Cancer Cells and Molecular Docking of Caspase-3. Antioxidants 2022, 11, 1514. [Google Scholar] [CrossRef]
- Ech Chahad, A. Satureja calamintha. In Lipids, Lipophilic Components Essent Oils from Plant Sources; Springer: London, UK, 2012; Volume 9, p. 507. [Google Scholar] [CrossRef]
- Cherrat, L.; Espina, L.; Bakkali, M.; Pagán, R.; Laglaoui, A. Chemical Composition, Antioxidant and Antimicrobial Properties of Mentha pulegium, Lavandula stoechas and Satureja calamintha Scheele Essential Oils and an Evaluation of Their Bactericidal Effect in Combined Processes. Innov. Food Sci. Emerg. Technol. 2014, 22, 221–229. [Google Scholar] [CrossRef]
- Labiod, R. Valorization of Essential Oils and Extracts of Satureja Calamintha Nepeta: Antibacterial Activity, Antioxidant Activity and Fungicidal Activity. Ph.D. Thesis, Université BADJI Mokhtar Annaba, Annaba, Algeria, 2016; 162p. [Google Scholar]
- Larrazabal-Fuentes, M.; Palma, J.; Paredes, A.; Mercado, A.; Neira, I.; Lizama, C.; Sepulveda, B.; Bravo, J. Chemical Composition, Antioxidant Capacity, Toxicity and Antibacterial Activity of the Essential Oils from Acantholippia deserticola (Phil.) Moldenke (Rica rica) and Artemisia copa Phil. (Copa copa) Extracted by Microwave-Assisted Hydrodistillation. Ind. Crops Prod. 2019, 142, 111830. [Google Scholar] [CrossRef]
- Saghrouchni, H.; El Barnossi, A.; Chefchaou, H.; Mzabi, A.; Tanghort, M.; Remmal, A.; Fouzia, C. Study the Effect of Carvacrol, Eugenol and Thymol on Fusariums Sp Responsible for Lolium Perenne Fusariosis. Ecol. Environ. Conserv. 2020, 26, 1059–1067. [Google Scholar]
- Piras, A.; Porcedda, S.; Falconieri, D.; Maxia, A.; Gonçalves, M.; Cavaleiro, C.; Salgueiro, L. Antifungal Activity of Essential Oil from Mentha Spicata L. and Mentha Pulegium L. Growing Wild in Sardinia Island (Italy). Nat. Prod. Res. 2021, 35, 993–999. [Google Scholar] [CrossRef]
- Medjdoub, A.R.; Benmehdi, H.; Oukali, Z. Chemical Composition And Antifungal Activity Of Essential Oil Of Satureja calamintha spp. Nepeta (L.) Briq against Some Toxinogenous Mold. NVEO-Nat. Volatiles Essent. Oils J. 2022, 9, 1981–2000. [Google Scholar]
- Iqbal, T.; Hussain, A.I.; Chatha, S.A.S.; Naqvi, S.A.R.; Bokhari, T.H. Antioxidant Activity and Volatile and Phenolic Profiles of Essential Oil and Different Extracts of Wild Mint (Mentha longifolia) from the Pakistani Flora. J. Anal. Methods Chem. 2013, 2013, 536490. [Google Scholar] [CrossRef] [PubMed]
- Božovic, M.; Pirolli, A.; Ragno, R. Mentha Suaveolens Ehrh. (Lamiaceae) Essential Oil and Its Main Constituent Piperitenone Oxide: Biological Activities and Chemistry. Molecules 2015, 20, 8605–8633. [Google Scholar] [CrossRef]
- Roy, A.; Park, H.J.; Abdul, Q.A.; Jung, H.A.; Choi, J.S. Pulegone Exhibits Anti-Inflammatory Activities through the Regulation of NF-Κb and Nrf-2 Signaling Pathways in LPS-Stimulated RAW 264.7 Cells. Nat. Prod. Sci. 2018, 24, 28–35. [Google Scholar] [CrossRef]
- Arteaga, J.F.; Ruiz-Montoya, M.; Palma, A.; Alonso-Garrido, G.; Pintado, S.; Rodríguez-Mellad, J.M. Comparison of the Simple Cyclic Voltammetry (CV) and DPPH Assays for the Determination of Antioxidant Capacity of Active Principles. Molecules 2012, 17, 5126–5138. [Google Scholar] [CrossRef]
- Rajčević, N.; Bukvički, D.; Dodoš, T.; Marin, P.D. Interactions between Natural Products A Review. Metabolites 2022, 12, 1256. [Google Scholar] [CrossRef]
- Flamini, G.; Cioni, P.L.; Puleio, R.; Morelli, I.; Panizzi, L. Antimicrobial activity of the essential oil of Calamintha nepeta and its constituent pulegone against bacteria and fungi. Phytother. Res. Int. J. Devoted Pharmacol. Toxicol. Eval. Nat. Prod. Deriv. 1999, 13, 349–351. [Google Scholar]

| Peak | Compounds | RI | EOSS | EOSD | |||
|---|---|---|---|---|---|---|---|
| CT | LT | R.T | Area (%) | R.T | Area (%) | ||
| 1 | α-Pinene | 939 | 939 | 7.885 | 1.21 | 7.894 | 0.90 |
| 2 | Sabinene | 970 | 975 | 9.020 | 0.49 | 9.025 | 0.39 |
| 3 | β-Pinene | 979 | 979 | 9.176 | 2.35 | 9.181 | 1.57 |
| 4 | o-Cymene | 1023 | 1026 | - | - | 10.563 | 0.31 |
| 5 | Limonene | 1026 | 1029 | 10.712 | 3.39 | 10.728 | 1.41 |
| 6 | Eucalyptol | 1030 | 1031 | 10.799 | 22.23 | 10.824 | 23.10 |
| 7 | Linalool | 1096 | 1096 | - | - | 12.798 | 0.25 |
| 8 | (+)-Isomenthone | 1163 | 1162 | - | - | 14.513 | 4.40 |
| 9 | Isomintlactone | 2422 | 2422 | 22.348 | 0.61 | - | - |
| 10 | Mintlactone | 1310 | 1314 | 23.736 | 2.37 | - | - |
| 11 | Menthol | 1171 | 1171 | 14.921 | 6.04 | 14.940 | 3.52 |
| 12 | Borneol | 1165 | 1169 | 14.995 | 2.63 | 15.010 | 1.76 |
| 13 | Trans-Isopulegone | 1590 | 1596 | 15.074 | 1.37 | 15.082 | 1.76 |
| 14 | Terpinen-4-Ol | 1172 | 1177 | 15.236 | 0.35 | 15.245 | 0.40 |
| 15 | Carvone oxide | 1260 | 1263 | 16.295 | 2.14 | 16.297 | 2.20 |
| 16 | Exo-2-Hydroxycineole | 991 | 991 | - | - | 16.585 | 0.26 |
| 17 | Pulegone | 1237 | 1237 | 16.891 | 12.00 | 16.928 | 12.44 |
| 18 | Piperitone Oxide | 1255 | 1256 | - | - | 17.340 | 5.37 |
| 12 | 4-Hydroxy-2,6,6-trimethyl-1-cyclohexenecarboxylic acid | 1699 | 1698 | - | - | 17.521 | 0.71 |
| 20 | Piperitenone | 1362 | 1368 | 17.745 | 0.58 | 17.748 | 0.26 |
| 21 | Isophytol acetate | 2215 | 2218 | - | - | 18.165 | 0.26 |
| 22 | Sabina ketone | 1154 | 1159 | - | - | 18.250 | 0.32 |
| 23 | Thymol | 1290 | 1290 | 18.531 | 3.06 | 18.319 | 2.15 |
| 24 | Carvacrol | 1299 | 1299 | 18.295 | 2.51 | 18.560 | 2.03 |
| 25 | 2,6,6-Trimethylbicylo [3.1.1]hept-2-ene | 942 | 945 | - | - | 18.641 | 0.31 |
| 26 | 2-Oxabicyclo[2.2.2]octan-6-one, 1,3,3-trimethyl- | 1031 | 1031 | - | - | 18.712 | 0.29 |
| 27 | γ-Diosphenol | 1105 | 1107 | - | - | 19.247 | 0.31 |
| 28 | Piperitenone | 1342 | 1343 | 19.653 | 3.18 | 19.669 | 2.16 |
| 29 | Rotundifolone | 1458 | 1459 | 20.236 | 10.49 | 20.288 | 9.68 |
| 30 | 2-Butylcyclopentanone | 1128 | 1128 | - | - | 20.350 | 0.22 |
| 31 | Tetrahydroactinidiolide | 1284 | 1288 | - | - | 20.441 | 0.36 |
| 32 | 5-Hepten-3-yn-2-ol,6-methyl-5-(1-methylethyl)- | 1458 | 1460 | - | - | 21.806 | 0.37 |
| 33 | Menthofurolactone | 1353 | 1353 | 19.890 | 2.40 | 19.916 | 2.98 |
| 34 | 4-(2-Methyl-cyclohex-1-enyl)-but-3-en-2-one | 786 | 786 | - | - | 23.615 | 1.01 |
| 35 | Mintlactone | 1310 | 1314 | 24.518 | 1.35 | 24.531 | 0.76 |
| 36 | 2-(2-Methyl-propenyl)-cyclohexanone | 1158 | 1158 | - | - | 24.965 | 0.41 |
| 37 | Peperinic acid | 1380 | 1380 | - | - | 25.216 | 0.37 |
| 38 | Spathulenol | 1577 | 1578 | 25.963 | 7.59 | 25.994 | 5.52 |
| 39 | Caryophyllene Epoxide | 1466 | 1466 | 26.145 | 1.50 | 26.162 | 1.27 |
| 40 | 2-Pentanone,4-hydroxy-4-methyl | 847 | 847 | 5.312 | 0.35 | - | - |
| 41 | l-Menthone | 1160 | 1162 | 14.507 | 2.26 | - | - |
| 42 | Menthofuran | 1164 | 1164 | 14.742 | 0.47 | - | - |
| 43 | (1S)-1,3,3-trimethylnorbornan-2-ol | 1160 | 1160 | 15.652 | 0.85 | 15.658 | 1.43 |
| 44 | Isobornyl formate | 1239 | 1239 | 16.651 | 0.31 | - | - |
| 45 | Carvone oxide | 1263 | 1263 | 17.313 | 1.93 | - | - |
| 46 | 7,11-Epoxymegastigma-5(6)-en-9-one | 1312 | 1312 | 17.998 | 0.43 | - | - |
| 47 | Cyclohexasiloxane, dodecamethyl- | 1350 | 1349 | 18.709 | 0.35 | - | - |
| 48 | 1-Isopropenyl-4-methyl-1,2-cyclohexanediol | 1090 | 1090 | 19.790 | 0.42 | - | - |
| 49 | Indene-1,7(4H)-dione,3a,7a-dihydro-5-methyl- | 1590 | 1590 | 20.155 | 0.47 | - | - |
| 50 | 3H-Naphtho[2,3-b]furan-2-one,4-hydroxy-4a,5-dimethyl-3-methylene-3a,4,4a,5,6,7,9,9a-octahydro- | 2014 | 2016 | 22.041 | 0.30 | - | - |
| 51 | 4-(2-Methyl-cyclohex-1-enyl)-but-3-en-2-one | 780 | 786 | 23.605 | 0.29 | - | - |
| 52 | 2,4-Bis-(tert.-butyl-)-phenol | 1513 | 1513 | 23.917 | 0.36 | - | - |
| 53 | Dinitropentamethylenetetramine | 1874 | 1876 | 43.160 | 0.33 | - | - |
| 54 | 3,6-Dimethyl-5,6,7,7a-tetrahydrobenzofuran | 1380 | 1380 | - | - | 14.751 | 0.64 |
| 55 | Isoborneol | 1160 | 1160 | - | - | 15.010 | 1.76 |
| 56 | Mintlactone | 1314 | 1314 | - | - | 23.755 | 1.42 |
| 57 | 3,6-Dimethyl-4,5,6,7-tetrahydrobenzofuran-2(3H)-one | 1380 | 1380 | - | - | 22.373 | 1.93 |
| Monoterpene hydrocarbons | 7.44 | 4.83 | |||||
| Oxygenated monoterpenes | 79.17 | 82.74 | |||||
| Sesquiterpene hydrocarbons | - | - | |||||
| Oxygenated sesquiterpenes | 9.72 | 7.43 | |||||
| Others | 2.63 | 3.97 | |||||
| Total identified (%) | 98.96 | 99.97 | |||||
| IC50 (μg/mL) | ||
|---|---|---|
| DPPH | FRAP | |
| EOSS | 23.030 ± 4.306 a | 55.382 ± 2.16 a |
| EOSD | 24.096 ± 4.381 a | 60.720 ± 7.71 a |
| Quercetin | 17.733 ± 1.788 b | 28.414 ± 0.06 b |
| EODS | EOSS | Streptomycin | ||
|---|---|---|---|---|
| Staphylococcus aureus ATCC6633 | Diameter of inhibition (mm) | 14 ± 0.00 a | 12.67 ± 0.58 b | 11 ± 1.00 c |
| MIC (µg/mL) | 5.96 ± 0.00 a | 5.96 ± 0.00 a | 1.56 ± 0.00 b | |
| Escherichia coli K12 | Diameter of inhibition (mm) | 25.67 ± 0.58 a | 48.67 ± 1.15 b | 0.00 ± 0.00 c |
| MIC (µg/mL) | 1.49 ± 0.00 a | 0.373 ± 0.00 b | - | |
| Bacillus subtilis DSM6333 | Diameter of inhibition (mm) | 18.67 ± 1.15 a | 25.67 ± 0.58 b | 0.00 ± 0.00 c |
| MIC (µg/mL) | 2.98 ± 0.00 a | 2.98 ± 0.00 a | - | |
| Proteus mirabilis ATCC29906 | Diameter of inhibition (mm) | 26.00 ± 1.73 a | 30.67 ± 1.15 b | 0.00 ± 0.00 c |
| MIC (µg/mL) | 1.49 ± 0.00 a | 1.49 ± 0.00 a | - | |
| EOSD | EOSS | Fluconazol | ||
|---|---|---|---|---|
| C. albicans ATCC-10231 | Diameter of inhibition (mm) | 47.33 ± 1.15 a | 40.00 ± 0.00 b | 0.00 ± 0.00 c |
| MIC (µg/mL) | 0.186 ± 0.00 a | 0.373 ± 0.00 b | - | |
| A. niger MTCC-282 | Percentage of inhibition (%) | 67.19 ± 0.00 a | 29.68 ± 2.71 b | 18.46 ± 2.02 c |
| MIC (µg/mL) | 1.49 ± 0.00 a | 0.373 ± 0.00 b | 7.125 ± 0.00 c | |
| A. flavus MTCC-9606 | Percentage of inhibition (%) | 41.27 ± 1.37 | 0.00 ± 0.00 | 0.00 ± 0.00 |
| MIC (µg/mL) | 0.746 ± 0.00 | - | - | |
| F. oxysporum MTCC-9913 | Percentage of inhibition (%) | 89.18 ± 0.75 a | 86.58 ± 0.76 a | 30.77 ± 0.58 b |
| MIC (µg/mL) | 1.49 ± 0.00 a | 2.98 ± 0.00 b | 3.125 ± 0.00 b | |
| Antioxidant Effect | Antimicrobial Effect | |||||
|---|---|---|---|---|---|---|
| PDB ID: 4EY7 | PDB ID: 1FJ4 | PDB ID: 3Q8U | ||||
| Glide Score (Kcal/mol) | Glide Energy (Kcal/mol) | Glide Score (Kcal/mol) | Glide Energy (Kcal/mol) | Glide Score (Kcal/mol) | Glide Energy (Kcal/mol) | |
| Eucalyptol | −5.58 | −24.743 | −5.7 | −21.613 | −4.172 | −14.205 |
| (+)-Isomenthone | −6.49 | −22.919 | −6.717 | −19.745 | −4.522 | −16.974 |
| MENTHOL | −6.722 | −21.106 | −6.855 | −18.662 | −5.392 | −18.125 |
| Pulegone | −7.647 | −22.115 | −7.099 | −24.36 | −5.067 | −18.027 |
| Piperitone Oxide | −7.01 | −23.687 | −6.399 | −22.343 | −5.479 | −21.285 |
| Piperitenone | −7.682 | −22.946 | −7.112 | −22.296 | −4.497 | −18.218 |
| Rotundifolone | −5.91 | −26.979 | −7.104 | −27.481 | −4.771 | −19.301 |
| Spathulenol | −7.011 | −26.214 | −5.982 | −20.041 | −4.795 | −17.187 |
Disclaimer/Publisher’s Note: The statements, opinions and data contained in all publications are solely those of the individual author(s) and contributor(s) and not of MDPI and/or the editor(s). MDPI and/or the editor(s) disclaim responsibility for any injury to people or property resulting from any ideas, methods, instructions or products referred to in the content. |
© 2023 by the authors. Licensee MDPI, Basel, Switzerland. This article is an open access article distributed under the terms and conditions of the Creative Commons Attribution (CC BY) license (https://creativecommons.org/licenses/by/4.0/).
Share and Cite
El Brahimi, R.; El Barnossi, A.; El Moussaoui, A.; Chebaibi, M.; Kachkoul, R.; Baghouz, A.; Nafidi, H.-A.; Salamatullah, A.M.; Bourhia, M.; Bari, A. Phytochemistry and Biological Activities of Essential Oils from Satureja calamintha Nepeta. Separations 2023, 10, 344. https://doi.org/10.3390/separations10060344
El Brahimi R, El Barnossi A, El Moussaoui A, Chebaibi M, Kachkoul R, Baghouz A, Nafidi H-A, Salamatullah AM, Bourhia M, Bari A. Phytochemistry and Biological Activities of Essential Oils from Satureja calamintha Nepeta. Separations. 2023; 10(6):344. https://doi.org/10.3390/separations10060344
Chicago/Turabian StyleEl Brahimi, Rajae, Azeddin El Barnossi, Abdelfattah El Moussaoui, Mohamed Chebaibi, Rabie Kachkoul, Asmae Baghouz, Hiba-Allah Nafidi, Ahmad Mohammad Salamatullah, Mohammed Bourhia, and Amina Bari. 2023. "Phytochemistry and Biological Activities of Essential Oils from Satureja calamintha Nepeta" Separations 10, no. 6: 344. https://doi.org/10.3390/separations10060344
APA StyleEl Brahimi, R., El Barnossi, A., El Moussaoui, A., Chebaibi, M., Kachkoul, R., Baghouz, A., Nafidi, H.-A., Salamatullah, A. M., Bourhia, M., & Bari, A. (2023). Phytochemistry and Biological Activities of Essential Oils from Satureja calamintha Nepeta. Separations, 10(6), 344. https://doi.org/10.3390/separations10060344

